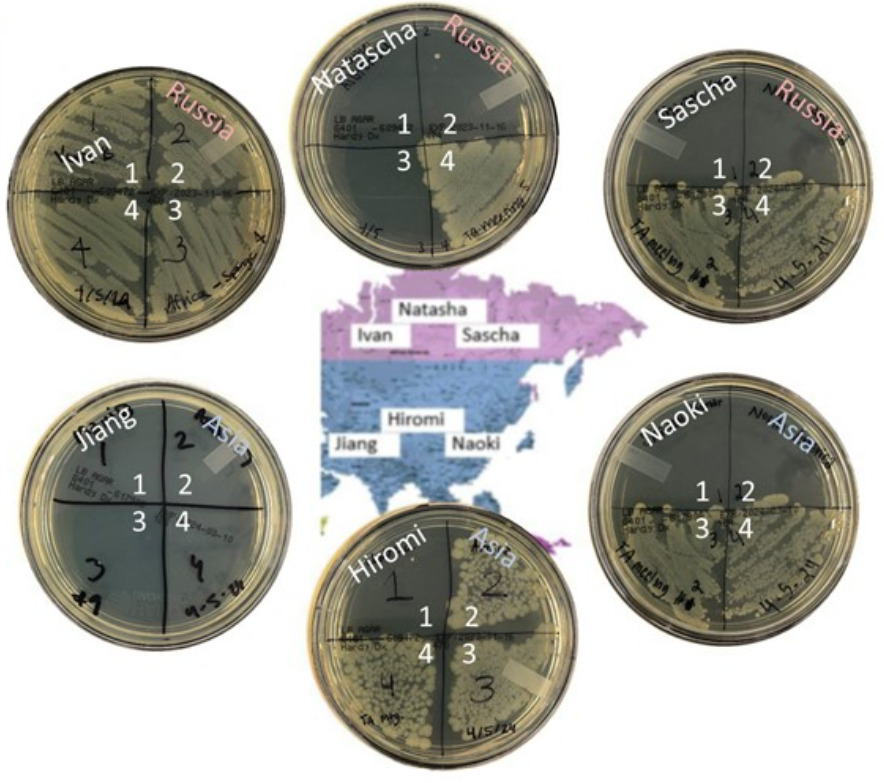

Lab C Beta-Galactosidase Assay
Lecture Quiz Part 1
questions:
1. For your first writing assignment (MIT) what is due in Week 3 and when
4 peer and 1 self reviews on friday noon
2. what is the primary purpose of luria broth in bacterial culture?
It provides essential nutrients for bacterial growth
3. which of the following is not a typical component of luria broth (LB)?
Carbon Source
4. what is the infection rate in this image?
5/6 → 83%
Based on what you know about the bacterial transmission activity, which of the following statements is NOT true based on the data shown in the image?
Sascha and Naoki shook hands in Round 3
Both Sascha and Naoki were not infected in rounds 1 and 2, so if they truly shook hands in round 3, both of them would still be uninfected.
6. What sugar is cleaved by beta-galactosidase
Lactose
7. Which simple sugars is lactose cleaved into?
Glucose and Galactose
8. Transcription is the process of making..
RNA from DNA
9. Translation is the process of making
Protein from RNA
10.What is one role of plasmids in bacteria?
carrying antibiotics resistance genes
11.The lac operon is e.coli is involved in
breakdown of lactose
12. The lac repressor
falls off the lac-operator when lactose is present
13. The enzyme b-Galactosidase is expressed when which sugar is present?
Lactose
Goal:
assay use
understanding lac operon
using micropipetters
Beta-Galactosidase Assay
B-galactosidase → an enzyme that breaks down lactose into monosaccharides
Measuring the actvity of enzymes by measuring rate of product synthesis & the time that was required
Due dates
lecture quizes
in lab quiz, lab worksheet, student presentation
post lab
4 peer & 1 Self evalutions @ friday at noon
Objective:
using the lac-operon
using the spectro-photometer
calculating enzyme activity
Lab Techniques
pipetter
cuvettes
culture tube
50 ml & 15 ml centrifuge tube
spectrophotometer
Microfuge tube rack
test tube rack
Cuvette rack
Luria Broth
Nutritionally rich medium for bacterial growth
has proteins, peptides, vitamins, trace elements,minerals
Who was patient Zero?
we have to figure out who was patient zero
a plate will have smaller bacterial colonies since theyre competing for resources and have bigger ones at the end
e.coli is kind of big and rounded
fungi has spores
Background Lecture
beta g will hydrolyze lactose
when there is no lactose then no beta g is made
a lot of glucose then there will be no beta g
Central Dogma
transcription and translation
DNA→ (transcription)→mRNA→ (translation)→protein
Gene Expression
e.coli has a circular chromosomes
Lac operon
Lac repressor
lac+ can digest lactose
Lac cannot digest lactose
Expression of the lac-repressor
RNA binds to the promoter
polymerase will transcribes lac I dna to mrna
translation into lac repressor
Blocking by the lac-repressor
Lac repressor binds to operator
RNA polymerase binds to binding site
its blocked
lactose binds to repressor for a conformational change which removes the repressor for expression to occur
beta-g converts lactose into allo-lactose that binds the the lac repressors to make it fall off and 10,000 to 20,000 molecules of beta will be expressed
no lactose, repressor activated
sometimes the repressor will be unbound and produce low levels of beta-g which will always occur
Lecture Quiz Part 2:
Question
1. In an ONPG assay, the development of a yellow color indicates
presence of beta-gal
1. When ONPG is hydrolyzed by β-Galactosidase, what is the yellow-colored product that forms?
Ortho-nitrophenol
2. For how long will the assay reaction be incubated for?
15 minutes
3. What type of blank should be used for the beta-gal assay?
Beta-gal blank made by your group
4. What type of blank should be used for the cell density reading test?
LB no bacteria read an 600 nm
5. What type of blank should be used for the beta-gal reading and at what wavelength should it read?
LB no bacteria, all assay chemicals, read at 420 nm
6. In calculating Miller Units, which factor is not directly considered?
OD420/time*volume*OD(600) ← is considered
temperature of the assay ← not considered
7. what is the purpose of the miller unit in the beta-gal assay?
To quantify beta-gal activity
running an assay
assay → measuring quantitatively or qualitatively the presence, amount or functional activity of a target entity
B-gal Assay
ONP (yellow) binds to galactose where when cleaved it will show a yellow color
If we get a color we can know that beta-g is in the medium
more enzyme → more activity, more product (more color)
less enzyme → less activity, less product
Cell Density:
Slightly Turbid→lower reading, less bacteria
ONP → otro-nitro-phenol (yellow color)
ONPG → Ortho- Nitro- Phenol- Galactoside (clear color)
OD420 → optical density reading at 420 nm (detects amounts of ONP
OD600 → turbity reading detects amount of bacteria
cell growth affect activity
No Induction Gene Expression is off:more cells and more enzymes → more activity which leads to a stronger color reaction over time
Induction Gene Expression is On: more enzyme per cell and more activity
Measuring Optical Density
to record assay → yellow color
420 nm purple (OD 420)
Cell Density, we use light scattering
600 nm (OD 600)
Product ONP has a linear increase over time
We’re letting it go for 15 minutes
bgal assay:
Transfer 100 microliters of bacterial culture (A,b,C0
add 10 microliters of popculture → opens up the cell for subtrate to enter
vortex for 30 secs
add 600 microliters of z buffer → normalizes the pH
140 microliters of ONPG → the substrate
incubate at room temp for 15 minutes
add 350 microliters (sodium-bi-carbonate)
Two Readings:
Enzyme Activity: (blank must be made by the group)
100 uL LB without bacteria + assay chemicals
100 uL LB with bacteria + assay chemicals
Cell Density: (LB blank is provided)
1 ML LB without bacteria
1 mL Lb with bacteria
production of beta gal without lactose (0.001)
off operon
(0.1-1) the production of beta-gal with lactose
on operon
Miller Units activity:
OD 420 reading of 0.5
OD 600 reading of 0.5
15 minutes duration
0.1 volume of bacteria in the assay
0.5/15×0.1×0.5=0.67 miller units
Lecture Video C:
Question 1:
1. The beta-galactosidase experimental setup will allow you to determine?
If E.Coli synthesizes beta-galactosidase in the presence of glucose
If the induction of beta-galactosidase synthesis is time dependent
If E.Coli synthesizes beta-galactosidase in the presence of lactose
If E.Coli synthesizes beta-galactosidase in the absence of any sugar source
2. In the beta-galactosidase experimental setup which setup should give a positive result?
LB & Lactose at the 70 minute time point
3. In the b-galactosidase assay lab, used microcentrifuge tubes and pipette tips contaminated with E. coli should be disposed of at the end of lab:
In the red autoclave bin provided in the fume hood
4. What is the purpose of PopCulture in this lab?
Partially disrupts cell wall to allow substrate to enter the cell
5. What is the purpose of z-buffer in this lab?
Provides an optimum pH for enzymatic reaction
6. What is the purpose of sodium-bi-carbonate in this lab?
Drastically changes the pH to stop the enzymatic reaction
7. In the Activity Assay, the Assay mix is incubated for how many minutes?
15 minutes
8. Bacterial growth and enzymatic activity are checked at which time-point?
20 & 70 min
9. What is the purpose of ONPG in this lab?
Substrate that gives a yellow color when cleaved
10. According to the Lab Safety Sheet provided for this week, which of the following is a potential hazard you will face in the b-galactosidase assay lab?
Risk Group 1 bacteria
11. Which of the following statements is false when using the spectrophotometer?
The lowest value the spectrophotometer will display is 0
12. Which of the following actions is least appropriate if you get a negative spec reading (< -0.01)?
Ignore the datapoint
Beta-gal will allow us to determine
If e.coli synthesizes the beta-gal in the absence of lactose, the substrate upon which beta-gal acts
LB control
Glucose,; lb and glucose
Lactose; lb and lactose → activated and will get a signal
If the induction of beta gal synthesis in e.coli is time dependent
incubae tubes at 37 degrees for 20 min
take subsample measure
incubate tubes at 37 degrees for another 50 minutes
take subsample measure
Procedure:
3 test tubes
A control
Glucose
Lactose
We will add 400 microliters of e.coli to each tube (label them)
incubate for 20 minutes, sub sample
Do a cell density reading OD600 for a, b,c
Do a beta-gal assay w/OD420
incubate for another 50 minutes, sub sample
Do a cell density reading OD600 for a, b,c
Do a beta-gal assay w/OD420
prepare cuvettes
13 cuvettes
6 microcentrifuge tubes
2 a tubes & 4 a cuv
2 b tubes & 4 b cuv
2 c tubes & 4 c cuv
1 cuv blank
microcentrifuge tubes, gloves, pippette tipes, cuvettes, culture tubes must be placed into the auto clave bin
Measure for Cell Density
take an aliquot from the growing cells and compare to the blank at 600 nm
take 100 microliters into vessel adding 10 microliters of pop cultrue and incubate for 10 minutes
add 600 microliters of bugge
140 microliterls of ONPG
incubate for 15 mintues
add 350 microliterls of sodium bicarbonate
will get a color reaction
Lab Manual
learn how to assay and ONPG substrate
Introduction
activation of an enzyme only when necessary
beta-gal hydrolysize lactose (energy source) to galactose and glucose
repressor is always being made
when lactose is present then the repressor will not be bound to the operator and beta-gal will be made
when lactose is not present then the repressor is bound to the operator and beta-gal is not made
glucose can be subsituted with o-nitro-phenol to make o-nitrophenyl-B-D-galactosidase (ONPG) that when cleaved will make colorless
Experiment
using ONPG as a substrate to assay beta-gal
miller units → Units = OD420/ (time X volume X OD600)
we need blanks to make measurements
Objective
if e.coli synthesize the enzyme beta gal in the absence of lactose
if there is a time dependent aspect
Pre-experiment Preparation
A (LB)
B (LB w. 400 uL of glucose)
C (LB w. 400 uL of lactose)
6 microcentrifuges for a b and c
4 cuv for a, 4 cuv for b, 4 cuv for c, 1 blank
Experimental Procedure
time zero, e. coli test tubes
pipette 400 uL into each a, b , and c tube
incubate for 20 minutes
time 20
mix
remove 1 ml from tube a and place into cuvette
assay
remove 100 microliters an add it to microcentrifuge tube a , b, and c